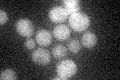
YML096W
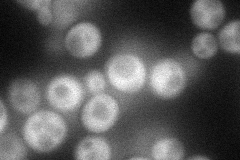
YML096W
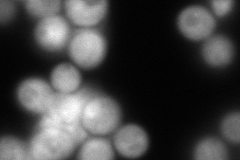
YML096W
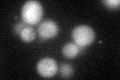
YML096W
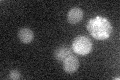
YML096W

View description
Putative protein of unknown function with similarity to asparagine synthetases; green fluorescent protein (GFP)-fusion protein localizes to the cytoplasm; YML096W is not an essential gene and partially overlaps the verified gene RAD10
Localization:
Intensity:
Fold change:
Significance:
-
C’ GFP library in SD
cytosol22.87 -
N' NOP1pr-GFP in SD
cytosol68.6845 -
N' TEF2pr-mCherry in SD
cytosol96.011 -
N' NATIVEpr-GFP in SD

below threshold20.7586 -
N' TEF2pr-VC and Cyto-VN in SD

cytosol34.7398 -
C’ GFP library in SD+DTT
cytosol23.821.04No -
C’ GFP library in SD+H2O2

cytosol23.511.02No -
C’ GFP library in Starvation Media
cytosol20.370.89No -
C’ GFP library on the background of Pup2-DaMP

cytosol -
C’ GFP library on the background of CCT mutant

cytosol27.86111.21768No
